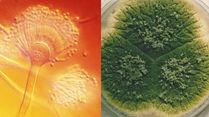
What Is Aspergillus? This Fungus Can Literally Eat You Alive, Can Turn Everyday Air Into A Health Risk

Pandemic
-
What Is Aspergillus? This Fungus Can Literally Eat You Alive, Can Turn Everyday Air Into A Health Risk
What Is Aspergillus? This Fungus Can Literally Eat You Alive, Can Turn Everyday Air Into A Health Risk -
 This Social Issue Could Be The Next ‘Epidemic,’ It Is Worse Than Smoking 15 Cigarettes A Day
This Social Issue Could Be The Next ‘Epidemic,’ It Is Worse Than Smoking 15 Cigarettes A Day -
 What Is Disease X? 20 Times More Deadlier Than Covid 19; Can Cause 50 Million Deaths, Does It Have Vaccine?
What Is Disease X? 20 Times More Deadlier Than Covid 19; Can Cause 50 Million Deaths, Does It Have Vaccine? -
 Kidulting: Where Adulthood and Nostalgia Collide in the Best Possible Way
Kidulting: Where Adulthood and Nostalgia Collide in the Best Possible Way -
 Antibiotic Resistance, Disease X, Flu: How India Is Gearing Up To Tackle The Next Likely Pandemic
Antibiotic Resistance, Disease X, Flu: How India Is Gearing Up To Tackle The Next Likely Pandemic -
 India Emerged Successfully In The Management Of Covid-19 Pandemic: Mansukh Mandaviya
India Emerged Successfully In The Management Of Covid-19 Pandemic: Mansukh Mandaviya -
 We Are Able To Predict Pandemic Based On Changes In Virus, Other Signals: Bharat Biotech Founder
We Are Able To Predict Pandemic Based On Changes In Virus, Other Signals: Bharat Biotech Founder -
 Covid-19 Not Over Yet Completely, Be Alert And Follow Govt's Guidelines: President Ram Nath Kovind
Covid-19 Not Over Yet Completely, Be Alert And Follow Govt's Guidelines: President Ram Nath Kovind -
 Covid-19 Pandemic Far From Over, 1.5 Million New Cases Daily, Says UN Secretary-General
Covid-19 Pandemic Far From Over, 1.5 Million New Cases Daily, Says UN Secretary-General -
 Covid Effect: Indian Consumers Now More Conscious Of Health, Fitness And Holistic Nutrition, Says EY Survey
Covid Effect: Indian Consumers Now More Conscious Of Health, Fitness And Holistic Nutrition, Says EY Survey -
 FDCI x Lakmé Fashion Week To Be Held In Delhi For The First Time In March 2022 In Physical Format
FDCI x Lakmé Fashion Week To Be Held In Delhi For The First Time In March 2022 In Physical Format -
 Risk Persists Even Though COVID Cases Starting To Plateau In Parts Of India: WHO
Risk Persists Even Though COVID Cases Starting To Plateau In Parts Of India: WHO
Notifications
Settings
Clear Notifications Notifications
Use the toggle to switch on notifications
- Block for 8 hours
- Block for 12 hours
- Block for 24 hours
- Don't block
Log in for Better Reading Experience!
By signing in, you agree to our Terms and Privacy Policy
Gender
Select your Gender
- Male
- Female
- Others
Age
Select your Age Range
- Under 18
- 18 to 25
- 26 to 35
- 36 to 45
- 45 to 55
- 55+



 Click it and Unblock the Notifications
Click it and Unblock the Notifications
